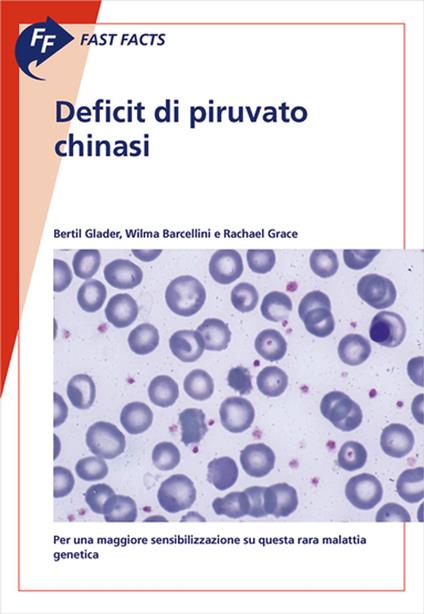
Fast Facts: Deficit di piruvato chinasi - Wilma Barcellini,Bertil Glader,Rachael Grace - ebook

Fast Facts: Deficit di piruvato chinasi
Lei potrebbe avere scarsa familiarità con il deficit di piruvato chinasi (PK). Si tratta di un raro difetto enzimatico ereditario che interessa la via glicolitica utilizzata dai globuli rossi per generare energia e che si manifesta come anemia emolitica. I sintomi variano notevolmente da un individuo all’altro, rendendo difficile la diagnosi, e le cure sono essenzialmente di supporto. Redatto da esperti nel settore, 'Fast Facts: Deficit di piruvato chinasi' fornisce un’introduzione completa alla malattia, tra cui informazioni dettagliate su: • difetto sottostante • modalità di trasmissione ereditaria e relazione tra genotipo e fenotipo • modalità di manifestazione della malattia • elementi diagnostici fondamentali e metodi di differenziazione del deficit di PK da un gruppo eterogeneo di malattie emolitiche • monitoraggio e gestione delle eventuali complicanze. 'Fast Facts: Deficit di piruvato chinasi' susciterà l’interesse di medici curanti, ematologi, oncologi, pediatri, specialisti in medicina interna, infermieri del reparto di ematologia e studenti di medicina: in realtà di tutto coloro che desiderano approfondire la propria conoscenza di questa rara malattia genetica del sangue.
-
Autore:
-
Editore:
-
Formato:
-
Lingua:Italiano
-
Cloud:
Formato:
Gli eBook venduti da Feltrinelli.it sono in formato ePub e possono essere protetti da Adobe DRM. In caso di download di un file protetto da DRM si otterrà un file in formato .acs, (Adobe Content Server Message), che dovrà essere aperto tramite Adobe Digital Editions e autorizzato tramite un account Adobe, prima di poter essere letto su pc o trasferito su dispositivi compatibili.
Cloud:
Gli eBook venduti da Feltrinelli.it sono sincronizzati automaticamente su tutti i client di lettura Kobo successivamente all’acquisto. Grazie al Cloud Kobo i progressi di lettura, le note, le evidenziazioni vengono salvati e sincronizzati automaticamente su tutti i dispositivi e le APP di lettura Kobo utilizzati per la lettura.
Clicca qui per sapere come scaricare gli ebook utilizzando un pc con sistema operativo Windows